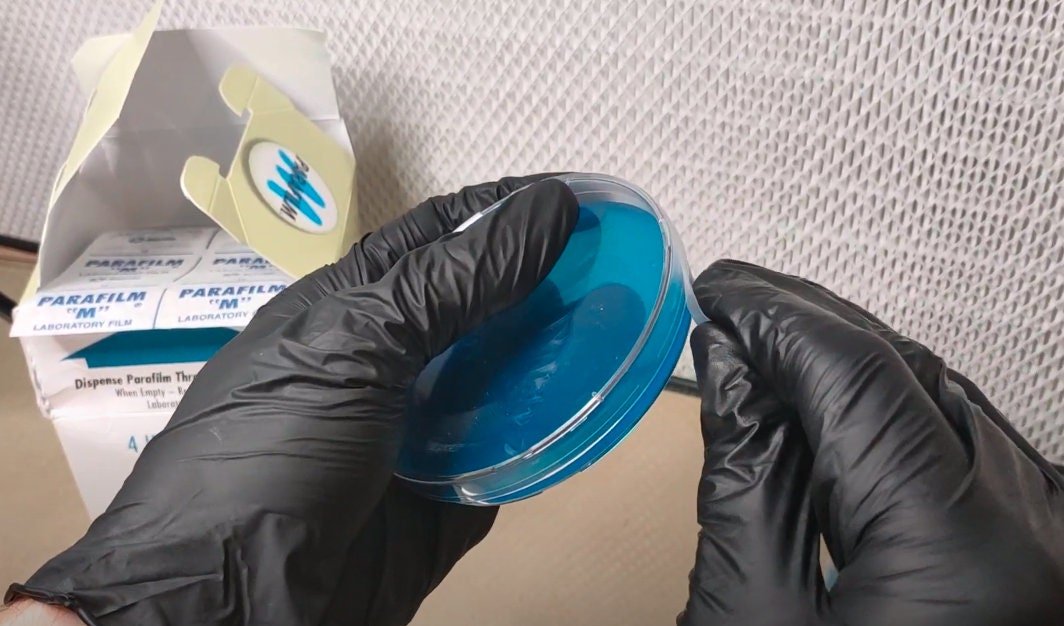

PARAFILM TAPE Laboratory Tape for Mycology and Petri Dishes 10 Feet
$8.00
You’re now subscribed to price tracking for this product. We’ll notify you if the price drops.
Fast Delivery
Quick, reliable shipping to any location.
Free & easy returns
Return this item by mail or in store within 90 days for a full refund.
🍄 Type M parafilm laboratory film. Superior to using micropore or grafting tape.
🍄 10 Feet of 2″ parafilm or 5 feet of 4″ parafilm – whichever we have in stock. Both can we used the same way and it is the same amount of material either way. Parafilm is cut into 8″ strips for shipping purposes.
🍄 Parafilm is ideal for petri dishes or used as masking in model painting. It also works great for covering beaker and media jar lids, and can be used to cover wide mouth and regular mouth mason jars as well. It is a breathable tape. It will not leave a residue when removed.
💌 Ships in a plain white letter mail envelope without tracking. Shipping estimates in Canada is around 1 week, USA and International is around 3 weeks.
Reviews
Related products

Reviews
There are no reviews yet.